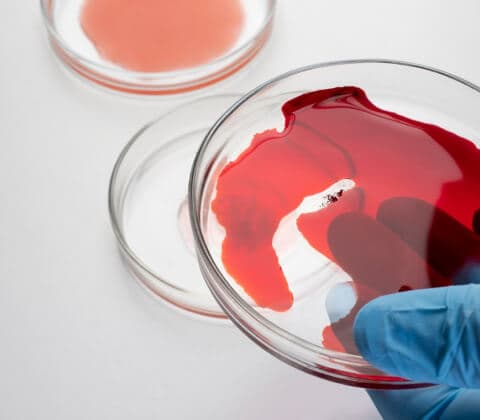
Hematology Overview

Expert Hematology and Oncology Services for Optimal Health
At MedStar Shah Medical Group, our dedicated team of Hematology and Oncology specialists is committed to delivering exceptional care across a range of blood disorders and cancers. We offer thorough evaluations, personalized treatment plans, and compassionate support tailored to each patient’s unique needs. Our goal is to manage and treat hematologic conditions, cancer diagnoses, and related health issues with the highest level of expertise and care.
Overview
Hematology and Oncology encompass the study and treatment of blood disorders and cancer. Hematology addresses issues such as anemia, clotting disorders, and leukemia, focusing on the health of blood cells. Oncology involves the diagnosis and treatment of various cancers, including solid tumors and hematologic malignancies. This specialty uses a multidisciplinary approach with treatments like surgery, chemotherapy, radiation, and targeted therapies. At MedStar Shah Medical Group, our Hematology and Oncology Center is equipped with advanced diagnostics and innovative treatments. Our expert team combines these resources to deliver personalized care that enhances outcomes and quality of life.

Causes of Blood Disorders and Cancers
- Genetic Factors: Inherited mutations or genetic variations.
- Environmental Exposure: Exposure to toxins and radiation.
- Lifestyle Factors: Risk from smoking, poor diet, and alcohol use.
- Immune System Issues: Autoimmune diseases or chronic inflammation.
- Pre-existing Conditions: Chronic illnesses and their treatments.
- Unknown Factors: Complex and not always identifiable causes.
Symptoms and Diagnosis
Recognizing symptoms of blood disorders and cancer early is essential for effective treatment. Comprehensive diagnosis involves reviewing medical history, conducting physical exams, and utilizing advanced tests to accurately identify and manage these complex health issues.
Symptoms of Blood Disorders:
- Fatigue: Persistent tiredness that may impact daily activities.
- Unusual Bleeding or Bruising: Unexpected bleeding or easy bruising.
- Frequent Infections: Increased susceptibility to infections.
- Anemia: Symptoms include paleness and shortness of breath.
- Swollen Lymph Nodes: Enlarged lymph nodes indicating potential issues.
Symptoms of Cancer:
- Unexplained Weight Loss: Sudden or significant weight loss without an obvious cause.
- Persistent Fatigue: Ongoing tiredness that doesn’t improve with rest.
- Pain or Discomfort: Unexplained pain or discomfort in various body parts.
- Changes in Skin Appearance: Alterations in skin color, texture, or unusual growths.
- Unusual Lumps or Swelling: Presence of new lumps or swelling in any part of the body.
Diagnosis:
- Medical History Review: Detailed discussion of patient history and symptoms.
- Physical Examination: Thorough examination to identify signs of blood disorders or cancer.
- Laboratory Tests: Blood tests, bone marrow biopsies, and other specialized tests.
- Imaging Studies: CT scans, MRI, PET scans, and X-rays to detect tumors and other abnormalities.
- Biopsies: Sampling tissue from suspicious areas for pathological examination.
Treatment
Effective treatment for blood disorders and cancer is vital for managing health and improving quality of life. Our comprehensive care approach addresses both immediate concerns and long-term health goals, utilizing advanced therapies and support strategies to manage symptoms and enhance overall well-being.
Our Approach to Hematology and Oncology Care
Our approach to hematology and oncology care emphasizes personalized and compassionate support tailored to each patient’s unique needs. We integrate cutting-edge treatments and a multidisciplinary team to ensure comprehensive care and effective management of both blood disorders and cancer.
Medical Care:
- Chemotherapy: Intravenous and oral chemotherapy treatments tailored to specific types of cancer.
- Radiation Therapy: Advanced radiation techniques to target and destroy cancer cells.
- Immunotherapy: Treatments that enhance the body’s immune system to fight cancer.
- Targeted Therapy: Medications that target specific molecules involved in cancer growth and progression.
- Bone Marrow and Stem Cell Transplants: Procedures to replace damaged bone marrow with healthy cells.
Lifestyle and Support Guidance:
- Nutrition Counseling: Dietary recommendations to support overall health and treatment outcomes.
- Exercise Recommendations: Safe and beneficial activities to maintain physical health.
- Emotional Support: Access to counseling and support resources for coping with diagnosis and treatment.
Patient Education:
- Health Information: Insights into managing blood disorders and cancer, including treatment options and side effects.
- Support Resources: Access to educational materials and support groups to aid in understanding and navigating your care journey.
Providers
Our hematology and oncology team comprises board-certified oncologists, hematologists, radiation oncologists, nurse practitioners, and supportive care specialists. Each member of our team is dedicated to providing compassionate care and utilizing the latest medical advancements to achieve the best possible outcomes for our patients.
Insurance and Payment Information
We accept a broad range of insurance plans to ensure that our patients can access the care they need without financial burden. For detailed information on accepted insurance plans and payment options, please contact our office directly. Our team is here to assist you with any questions regarding insurance and billing.
Patient Success Stories
Discover the remarkable stories of our patients who have triumphed over hematologic and oncologic challenges. Their journeys showcase the compassionate care and innovative treatments at MedStar Shah Medical Group, demonstrating how our dedicated approach has made a meaningful difference in their lives.
Frequently Asked Questions
What role does supportive care play in managing cancer treatment?
Consult your provider for tailored support strategies. Generally, supportive care includes managing symptoms, providing nutritional support, and offering counseling to improve quality of life and assist with the emotional and physical challenges of cancer treatment.
How do treatment approaches differ for various types of cancer?
Speak with your oncologist for personalized treatment plans. Generally, treatment approaches vary based on the type and stage of cancer, and may include surgery, chemotherapy, radiation therapy, and targeted therapies tailored to specific cancer types.
What are some common blood disorders and how are they diagnosed?
Enhance Your Hematology and Oncology Care
Your journey to better health starts with a proactive approach to managing hematologic and oncologic conditions. At MedStar Shah Medical Group, we’re dedicated to providing expert care and compassionate support to help you navigate your health journey with confidence.
Thank you for choosing us to be part of your care team. We look forward to partnering with you for a healthier future.